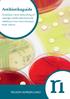
Antibiotikaguide. Anbefalet initial behandling af udvalgte samfundserhvervede infektioner hos immunkompetente

Ordinær eksamen (med svar) 6. semester Vinter 2004/2005
|
|
|
- Augusta Mørk
- 10 år siden
- Visninger:
Transkript
1 Ordinær eksamen (med svar) 6. semester Vinter 2004/2005 TEMA A. Infektionssygdomme og mikrobiologi Infektionssygdomme 52-årig mand indlægges akut med feber af to dages varighed og åndenød. Objektivt er patienten vågen, men konfus. Har en temp. på 39,1 C og en respirationsfrekvens på 30. Der er spredt krepitation bilateralt på bagfladerne ved lungestetoskopi. Er hjemkommet for tre dage siden fra 14 dages chartertur til Tyrkiet. 1. Angiv 3 mulige årsager til patientens symptomer. pneumoni, meningitis, sepsis) 2. Angiv de 6 vigtigste indledende parakliniske undersøgelser. a-punktur, bloddyrkning, røntgen af thorax, ekspektorat eller trakealsug til mikroskopi og dyrkning, lumbalpunktur, hæmatologi (hæmoglobin, leukocyttal og differentialtælling, thrombocyttal), levertal (alat eller asat, basiske fosfataser, faktor II, V, VII, LDH, bilirubin og albumin), creatinin, carbamid, elektrolytter (Na, K) og CRP) 3. Røntgen af thorax viser bilaterale interstitielle infiltrater. Blodprøver: normal hæmatologi, hyponatriæmi (115 mmol/liter) og let leverpåvirkning (ALAT x 3 forhøjet, normal pp) og CRP (c-reaktivt protein) på 320 mg/liter. Hvad er den mest sandsynlige ætiologi til infiltraterne? og hvorfor? legionella pneumoni, karakteristisk med interstitielle forandringer, hyponatriæmi, konfusion og endvidere eksposition i form af ophold på hotel i Tyrkiet) 4. Nævn 3 ætiologiske differentialdiagnoser. pneumokokker, chlamydia pneumonia, chlamydia psittacia, mycoplasma pneumonia) 6.sem. ord. 04/05 1
2 5. Hvordan vil du stille diagnosen? trakealsekret/ekspektorat til undersøgelse vha PCR for legionella, LUT(= legionella antigen i urin)) 6. Angiv de 3 vigtigste antibiotika, som alene eller i kombination anvendes til behandling af sygdommen. makrolid evt suppleret med ciprofloxacin eller rifampicin) 7. Hvilken understøttende behandling kan blive nødvendig? ilt-tilskud, respirator, dialyse) 8. Det viser sig, at patienten er HIV positiv og har et dårligt immunforsvar (CD4 tal 130 x 10 6 /liter). Giver dette anledning til overvejelse af yderligere differentialdiagnoser? ja, pneumocystepneumoni) 6.sem. ord. 04/05 2
3 Mikrobiologi - Bakteriologi Røntgenbilledet var taget mens patienten lå i sengen og var derfor af dårlig kvalitet. Næste dag tages et nyt røntgenbillede, som viser venstresidig lobær pneumon, og mikroskopi af ekspektoratet viser talrige Gram-positive diplokokker i strøg med leukocytter og cylinderepitelceller, og dyrkningen viser vækst af pneumokokker. 1. Angiv pneumokokkernes vigtigste virulensfaktor, og angiv, hvad denne virulensfaktor består af, og hvorledes den fremmer pneumokokkernes virulens og hvilke værtsfaktorer, der kan modvirke denne virulensfaktors effekt. kapslen, polysakkarid, den forhindrer fagocytose, antistoffer mod kapslen) 2. Angiv på hvilket grundlag pneumokokkerne typeinddeles, hvilken teknik, der anvendes til typningen, og omtrentlig hvor mange typer, der findes, og hvilken infektionsmæssig betydning det har. kapselpolysakkarid, kapselsvulst med specifikt antiserum mod kapslen, ca. 80 typer, man kan få mange pneumokokinfektioner med forskellige typer) 3. Angiv hvad der er de antigene komponenter i pneumokokvaccinen og en patientgruppe, som i Danmark skal tilbydes vaccination, og begrund indikationen. kapselpolysakkarider, patienter, der skal have fjernet milten, som har risiko for fulminant pneumokoksepsis) 4. Angiv hvor i legemet man kan finde pneumokokker som del af normalfloraen, hos raske mennesker. næsesvælgfloraen) 5. Angiv 3 andre infektionssygdomme, som pneumokokker er blandt de hyppigste årsager til. akut otitis media, sinusitis, meningitis, sepsis, akut exacerbation af kronisk obstruktiv lungesygdom (kronisk bronkitis = KOL = COPD) 6.sem. ord. 04/05 3
4 6. Angiv hvilket antibiotikum, der hyppigst anvendes til behandling af pneumokokinfektioner i Danmark, og dets virkningsmekanisme samt resistensmekanismen hos pneumokokkerne overfor dette antibiotikum. penicillin, hæmmer cellevægssyntesen = hæmmer transpeptidaserne (penicillinbindende proteiner) ved krydsbindingen af peptidoglycanmolekylerne i cellevæggen. Ændrede penicillinbindende proteiner = nedsat affinitet af transpeptidaser overfor penicillin) 7. Angiv dette antibiotikums farmakodynamiske/farmakokinetiske virkning (koncentrationsafhængigt eller tidsafhængigt bakteriedrab?) og hvordan man derfor bedst doserer det pågældende antibiotikum. tidsafhængigt bakteriedrab, dvs. hyppig dosering (evt. endnu finere men kræves ikke: koncentrationen af antibiotikummet > bakteriens MIC (mindste hæmmende koncentration = følsomhedsniveau ) i mindst 50% af dosisintervallet) (OBS: hvis studenten har svaret et forkert antibiotikum i spgm. 6, som dog har effekt overfor pneumokokker dvs. cefalosporin eller et makrolid (erytromycin, azithromycin, clarithromycin, roxithromycin osv.), så vil et rigtigt svar for dette antibiotikum blive godkendt i spgm. 7!) Svampe Under antibiotikabehandlingen udvikler patienten hvide belægninger på tungen. Podning fra belægningerne viser vækst af Candida albicans. 1. a. Angiv årsagen til at denne slimhindeinfektion fremkommer hos patienten. den bakterielle normalflora er udryddet af antibiotikabehandlingen, da Candida er resistent overfor antibakterielle antibiotika vokser de frem som superinfektion af slimhinden, patienten kan have en cellulær immundefekt) b. Nævn 2 antibiotika, som Candida albicans er følsom overfor, og som kan anvendes til at behandle svære systemiske infektioner med denne svamp. amfotericin B, fluconazol, itraconazol) 6.sem. ord. 04/05 4
5 Parasitologi Patienten bliver med god klinisk effekt behandlet for sin akutte lungesygdom, men får ca. 3 uger efter igen feber ledsaget af smerter under højre curvatur. Ved klinisk undersøgelse findes hepatomegali og ømhed i øvre højre del af abdomen. Ved nærmere udspørgning af patienten viser det sig, at han under opholdet i Tyrkiet havde en episode med blodige diarreer, der spontant forsvandt. 1. a. Hvilken parasit er den mest sandsynlige årsag til sygdomsforløbet? Entaemobae histolytica) b. Angiv livscyklus og smitteveje for denne parasit samt baggrunden for parasittens patogenicitet. To stadier: cystestadiet, som udskilles med fæces og som forårsager smitte via den fæcal-orale rute; trofozoitstadiet: som parasitten omdannes til i tarmen og som forårsager sygdommen. Parasitten producerer enzymer, der nedbryder væv og den kan derfor invadere tarmvæggen og herfra spredes til andre organer) 2. Hvis vi antager, at sygdommen er forårsaget af denne parasit, hvad er så den mest sandsynlige diagnose, og hvilke undersøgelser vil du foranstalte for at bekræfte diagnosen? Lever amoebe abces/celle nekrose; fæcesmikroskopi, ultralyd af abdomen (eller anden billeddannelse) evt med aspiration af abces materiale som mikroskoperes, serologisk påvisning af IgG (amoebe IHAT = indirekte hæmagglutinations test) positiv i 96% af patienter med amoebe abces) 6.sem. ord. 04/05 5
6 Virologi Patienten er fundet inficeret med HIV. 1. Angiv hvorledes diagnosen HIV infektion stilles, samt hvor lang tid der kan gå efter smitteudsættelse, inden denne analyse sikkert påviser infektion. påvisning af HIV specifikke antistoffer ved ELISA samt Western blot. Der kan gå op til 3 mdr, inden denne analyse er positiv. Evt. kan man påvise virusantigen tidligt i forløbet.) 2. Beskriv kort patogenesen ved HIV infektion. ( HIV inficerer primært CD4+ T celler, hvorfor antallet reduceres gradvist over en årrække. Følgen er, at pt. s evne til at rejse cellemedierede immunsvar ophæves ligesom evnen til at danne nye antistoffer forsvinder. Som følge heraf bliver pt modtagelige for ellers lavpatogene eller uskadelige infektiøse agentia). 3. Angiv hvorledes patientens immunstatus monitoreres. Pt. s immunstatus vurderes ved indholdet af CD4+ T celler i blodet.) 4. Angiv hvorledes patientens virusniveau (virusload/virusbelastning) monitoreres. Virusniveauet vurderes ved RT (revers transcriptase)-pcr, der bestemmer antallet af infektiøse viruspartikler i blodet (indeholder virus-kodet RNA)). 5. Gør kort rede for 3 forskellige angrebspunkter for de stoffer, der anvendes i anti-retroviral kemoterapi. Revers transkriptase hæmmere: nucleosidanaloger eller non-nucleosidinhibitorer hæmmer virusreplikationen; proteasehæmmere hæmmer dannelsen af nye infektiøse viruspartikler, fusionshæmmere hæmmer fusionen af viruspartiklerne ind i cellen.) 6.sem. ord. 04/05 6
7 HERTIL FØJES SPØRGSMÅL FRA DE PARAKLINISKE FAG OG FRA PANUMFAGENE Radiologi (Thomsen) 1. Angiv 3 faktorer, man lægger vægt på ved vurdering af infiltrat i lungerne ved en røntgenundersøgelse af thorax. Tæthed, afgrænsning og placering) Farmakologi 1. Redegør for virkningsmekanismerne for de muligt anvendte antibakterielle lægemidler jvf. spørgsmål 6 i infektionsmedicin (dvs. for de antibiotika, der ville kunne anvendes under spørgsmål 6). Makrolid (stofeksempel erythromycin) hæmmer den bakterielle proteinsyntese ved at binde til det bakterielle ribosom og hæmmer herved translokationen. Fluoroquinoloner- (stofeksempel ciprofloxacin / ciproxin) hæmmer den bakterielle DNA-syntese ved at hæmme enzymet Topoisomerase II. Topoisomerase II er en gyrase, der inducerer negativ supercoiling i DNA et (folder DNA et ud) hvorved replikation og transkription muliggøres. Rifampicin hæmmer den bakterielle nukleinsyre syntese ved at binde til og herved hæmme den bakterielle RNApolymerase (en DNA-afhængig RNA-polymerase).) Epidemiologi På samme afdeling indlægges over sommeren 3 patienter med svære influenza-lignende symptomer, få dage efter at have besøgt den samme restaurant. Årsagen viste sig at være en sjælden manifestation af Legionella. Via embedslægen identificeredes yderligere 170 gæster ud af de flere tusinde, som spiste i restauranten i samme periode. Alle 173 personer blev interviewet. I alt 117 havde haft symptomer, der opfyldte kriterierne for en case (feber samt mindst et af en række symptomer, <5 dage efter besøget), mens 56 ikke havde haft symptomer. Der var ingen sammenhæng mellem specifikke fødevarer/retter og sygdom. Men 68 af de 117 syge, og kun 10 af de 56 raske, havde siddet nær ved et springvand under måltidet. 1. Hvilket studiedesign anvendes, når ikke alle gæster blev fulgt op? case-control) 6.sem. ord. 04/05 7
8 2. Hvilket mål for sammenhængen mellem eksponering, dvs. at have siddet nær springvand, og sygdom kan udregnes? odds ratio) (OR). 3. Udregn dette associationsmål, og forklar hvordan det fortolkes. OR=6.4. Det betyder, at risikoen blandt eksponerede er mere end 6 gange større end blandt ueksponerede. Korrekt opstillet regnestykke (68x46)/(49x10) uden facit accepteres også.) 4. Hvilket mål angives altid i parentes efter et sådant estimat, og hvordan skal det fortolkes? 95% konfidensgrænser. Det er et mål for usikkerheden på estimatet pga. stikprøvevariation, og angiver indenfor hvilket interval den sande værdi formentlig ligger) 5. Hvad var formålet med denne undersøgelse? at identificere og dekontaminere smittekilden, og dermed forebygge yderligere tilfælde) 6.sem. ord. 04/05 8
9 TEMA B. Lungesygdomme 29-årig mand henvist til udredning for hoste. Han har gennem de sidste 4 uger efter en lettere halsinfektion haft tør irritativ hoste og åndenød. Symptomerne kan forværres ved anstrengelse, temperaturskift og ved udsættelse for stærke dufte eller røg. 1. Angiv 2 nedre luftvejssygdomme, som kan debutere på denne måde. 1. Viral infektion 2. Astma 3. Atypisk lungeinfektion med Mycoplasma pneumonia 4. Sarkoidose 5. Löffler s syndrom) 2. Hvilket undersøgelsesprogram ville være relevant? Angiv 5 undersøgelser. 1. Spirometri med reversibilitetstest for beta 2 -agonist 2. Peak-flow registrering gennem 2-4 uger 3. Røntgen af Thorax 4. Undersøgelse for antistoffer mod Mycoplasma pneumoniae. 5. Leukocytter med differentialtælling i blod 6. Allergi priktest 7. Metacholin provokation, eller anden direkte provokation 8. Anstrengelses provokation (løbebånd, eller cykel) 9. Eucapnisk hyperventilationstest 10. NO måling i udåndingsluften 11. Field test 12. Måling af flow-volumen kurve 13. Udvidet lungefunktion med TLC (Total lungekapacitet) og DCO (diffusionskapacitet), samt evt. sgaw (specifikke modstand) og Raw (modstand) 14. Alfa1-antitrypsin 3. Hvilke 3 kriterier skal være opfyldt for at kunne diagnosticere astma? 1. Symptomer på astma (hoste, åndenød, hvæsen/piben, trykken for brystet) 2. Obstruktivt nedsat lungefunktion 3. Reversibilitet enten spontant eller efter astma behandling) 6.sem. ord. 04/05 9
10 4. Angiv 4 lungefunktionstest, som kan indgå i diagnosen af astma, og kriterierne for, at testen er positiv. 1. Reversibilitet efter beta 2 -agonist på mindst ml (12% af pred) 2. Reversibilitet efter glucocorticoid på mindst 500 ml 3. Mindst 20% variation i Peak-flow målingerne morgen/aften over 2-4 uger 4. Mindst 20% reduktion i FEV 1 efter inhalation af agens (PD20 eller PC20) Mindst 15-20% reduktion i FEV 1 efter løb på løbebånd med 10 graders hældning eller field test Mindst 10% reduktion i FEV 1 efter eukapnisk hyperventilation) 5. Hvilke undersøgelser kan anvendes til at vurdere en anamnestisk mistanke om inhalationsallergi? Angiv 2 undersøgelser. 1. Hud priktest med allergener 2. Specifik IgE-måling, (RAST test) 3. Organ (øjne, næse, lunger) provokation med kendt allergen 4. Histamin realease (basophil histaminfrigørelse)) 6. Hvilke 2 kriterier skal være opfyldt for, at der er tale om allergisk astma? Astma symptomer ved kontakt/udsættelse for det relevante allergen. Positiv priktest, specifik IgE måling eller provokationstest med relevant allergen) 7. Hvordan klassificeres sværhedsgraden af astma. I henhold til GINA klassifikation (GINA 1, 2, 3 og 4) ) 8. Hvilken farmakologisk behandling af astma er indiceret, når den pågældende patient har natlige symptomer (> 2 gange om måneden) og en PEF variation på 20-30%? Patienten har symptomer svarende til GINA 2 hvilket er fast behandling med: 1. Inhalations-glucocorticoid i lav til moderat dosis Evt suppleret med: 2. Leukotrienhæmmere (specielt ved anstrengelsesudløst astma)) 6.sem. ord. 04/05 10
11 Patienten ringer til dig, fordi han er forkølet uden feber og får en forværring med natlige symptomer 2-3 gange per uge, og han måler en peak-flow variation på over 30%. 9. Hvad vil du anbefale patienten? Øge behandlingen i henhold til GINA. Da han nu har natlige symptomer, og variation i peakflow har patienten symptomer forenelig med moderat til svær astma (GINA 3-4) og behandlingen skal justeres i henhold til dette. Det kunne indebære langtidsvirkende beta 2 -agonist peroral behandling, i fald øget inhalations behandling ikke er tilstrækkeligt.) Patienten har positiv priktest overfor støvmider og græs. 10. Hvilke specifikke behandlingsmuligheder er der? 1) Undgå eller reducere udsættelse for relevant allergen, fx støvmide sanering. 2) Allergi vaccination mod klinisk relevante allergener) 11. Angiv mindst 2 terapeutiske effekter af allergi vaccinationer. 1. Færre symptomer 2. Færre dage med allergi symptomer 3. Mindre behov for medicin 4. Mindre risiko for udvikling af forværring i sygdommen 5. Mindre risiko for udvikling af nye allergier) HERTIL FØJES SPØRGSMÅL FRA DE PARAKLINISKE FAG OG FRA PANUMFAGENE Patologisk anatomi 1. Beskriv de patogenetiske mekanismer ved allergisk astma. IgE medieret hypersensitivitetsreaktion type I med frigørelse af histamin, leukotriener etc. medførende glatmuskelcellekontraktion og øget slimsekretion, inflamation) 6.sem. ord. 04/05 11
12 Radiologi 1. Hvad er det hyppigste fund ved røntgenundersøgelse af thorax hos en patient med astma? Normale forhold vedr. hjerte og lunger) Farmakologi 1. Angiv 3 typer lægemidler, som det kan være farligt at anvende hos astmatikere, og beskriv kort mekanismen for de farlige bivirkninger hos astmatikere. Beta-blokkere (fx propranolol) - kan virke bronkokonstriktorisk ved blokade af beta-2-adrenerg stimulation. Kan også ses med beta-1-blokkere, da disse ikke er helt selektive. Opioides (morphin o.lign.) - hæmmer respirationen ved depression af respirationscentret og evt. ved bronkokonstriktion (pga. histaminfrigørelse fra mastceller). Den hostestillende effekt kan tillige være problematisk. Barbiturater og andre respirationsdeprimerende lægemidler - pga. respirationsdepression. Acetylsalicylsyre samt de øvrige NSAID (vel næppe selektive COX-2 hæmmere) - kan udløse astmaanfald, hvilket antages at bero på øget leukotrien-syntese pga. COX-hæmningen (intolerance). Kolinerge (muskarine) agonister - bronkokontraherende ved stimulation af muskarine receptorer og øger sekretionen. Hostestillende midler - kan give anledning til sekretophobning og dermed øget infektionsrisiko samt yderligere besværet respiration.) Mijømedicin 1. Angiv 3 vigtige komponenter i udendørs luftforurening, der kan forværre astma, samt deres tilstandsform og angrebspunkt i luftvejene. Kvælstofdioxid: gas, nederst i konduktive luftveje og alveoler Ozon: gas, nederst i konduktive luftveje og alveoler Partikler: aerosol, større partikler->4 µm i øvre luftveje; <4 µm i nedre luftveje; <0.5 µm også i alveoler Svovldioxid: gas, konjunktiva, øvre luftveje og øvre konduktive luftveje (det sidste er ikke længere relevant for astma i Danmark)) 6.sem. ord. 04/05 12
13 TEMA C. Endokrinologi 72-årig kvinde indlægges akut pga. pludselige kraftige rygsmerter opstået ved foroverbøjning, hvor pt. forsøgte at løfte en gulvspand. Akut røntgenbillede af columna thorakolumbalis viser sammenfald af corpus thorakalis 12, hvor forkanten er reduceret 30% i forhold til bagkanten. (Ingen mistanke om cancer.) 1. Hvad er patientens mest sandsynlige diagnose? postmenopausal osteoporose) 2. Angiv 6 risikofaktorer for denne sygdom. genetisk disposition, tidlig menopause, hypogonadisme, lav vægt (BMI< 19), nedsat calciumindtag, nedsat vitamin D indtag, behandling med binyrekarkhormoner, hyperthyreoidisme, tobaksrygning, stort alkohol indtag, øget faldtendens, tidligere lavenergi fraktur, nedsat fysisk aktivitet, malabsorption, kronisk inflammatoriske sygdomme i bevægeapparatet, tyndtarms inflammation, kronisk obstruktiv lungesygdom, nyreinsufficiens, leverinsufficiens) 3. Angiv de diagnostiske kriterier for sygdommen ved fraktur og ud fra DEXA-skanning. lavenergifraktur undtagen af hænder, fødder og cranium, i columna sammenfald af corpus >20%. Ved DEXA T-score < - 2,5) 4. Patienten er tidligere rask. Hvilke muligheder er der for knoglemedicinsk behandling? som basis tilstrækkeligt med calcium mg og vitamin D IE, SERM (selektiv estrogen receptor modulators), bisfosfonater, PTH (parathyreoideahormon) 1-34, eventuelt vertebro/kyfo-plastik) 5. Hvordan følges behandlingseffekten, og hvornår gøres dette? Gøres ved klinisk kontrol og DEXA-skanning efter 2-3 år) 6.sem. ord. 04/05 13
14 HERTIL FØJES SPØRGSMÅL FRA DE PARAKLINISKE FAG OG FRA PANUMFAGENE Patologisk anatomi 1. Hvad forstås ved en osteolytisk proces i knogle? Knoglenedbrydende proces (= osteoklaststimulerende proces).) 2. Osteolytisk proces i knogle kan skyldes primær eller sekundær neoplasi, hvad er forskellene? Primær svulst opstået fra celler i knoglemarv eller knoglesekundær metastase) Radiologi 1. Den 72-årige kvinde havde sammenfald af corp. thoracalis 12, reduktion af forkanten i forhold til bagkanten på 30%. a) Hvad er de differentialdiagnostiske overvejelser, og b) hvordan kommer man diagnosen nærmere? a: osteoporotisk sammenfald, fraktur, osteolytisk metastase, hæmangiom, knogletumor. b: MR-skanning) Klinisk fysiologi/nuklearmedicin 1. Angiv 3 fælles skintigrafiske karakteristika for metastaser til knoglesystemet fra cancer mammae og cancer prostatae. Metastaser fra cancer mammae og cancer prostatae til knoglesystemet har en række skintigrafiske fælles karakteristika: Kraftig aktivitet (stor aktivitet i knoglenedbrydning-/knogleopbygningscyklus). Multipel metastasering i centrale skelet (evt. dalmatiner-udseende). Asymmetrisk placering (evt. mølædte ribben). Superscan (så kraftig aktivitet, at den relative aktivitetsoptagelse i nyrerne ikke er synlig)) 6.sem. ord. 04/05 14
15 Klinisk Biokemi Det viser sig, at patienten har glukosuri, og hun mistænkes derfor også for at have diabetes mellitus. 1. Angiv hvad C-peptid er. (Svar. Det tredje fragment af proinsulin. De to andre er A- og B-kæderne i proinsulin, der kobles sammen til insulin i pandreas beta-celler) 2. Angiv 3 sygdomme, hvor C-peptid koncentrationen i plasma anvendes diagnostisk. C-peptid måles i plasma ved mistanke om type-i diabetes mellitus, da C-peptid bedre end insulin markerer de pancreatiske beta-cellers evne til at producere insulin. C-peptid målinger anvendes endvidere ved diagnostik af insulinomer, insulin-producerende tumorer, kan evt. benyttes i klassifikationen af om patienten har type 1 eller type 2 diabetes) Farmakologi 1. Beskriv virkningsmekanismerne for og effekten af 4 grupper af farmaka, der kan anvendes til forebyggelse af postmenopausal osteoporose, og gør rede for disses 4 vigtigste bivirkninger. 1. Vitamin D/calcium tilskud: Virkningsmekanisme og effekt: Vitamin D stimulerer rekruttering og aktivering af osteoklaster Samtidig stimulatorisk effekt på knogledannelse, på absorption af calcium fra tarmen samt på reabsorption af calcium i nyrerne. Hæmmer sekretion af PTH. Calcium tilskud vedligeholder knoglemineralindholdet. Desuden forebygger calcium kombineret med vitamin D knogletabet hos ældre af begge køn over 65 år og reducerer risikoen for perifere frakturer. Bivirkninger: Vitamin D: Hypercalcæmi ledsaget af kvalme, opkastninger, vægttab, hovedpine, apati, træthed, konfusion og nyrepåvirkning. 2. Selective estrogen receptor modulators (SERM) (raloxifen): - Partiel agonist på ER og ren antagonist på ER - hæmmende effekt på mammavæv og endometrium - nedsætter plasmalipider og øger knogletæthed Bivirkninger: Øget risiko for DVT (dyb venetrombose) og behandling kan udløse/forværre klimakterielle gener. 3. Bifosfonater: Bisfosfonater (alendronat og etidronat): Virkningsmekanisme og effekt: Syntetiske pyrofosfatanaloger. Bindes til knoglemineral og hæmmer knogle turnover. Sætter knogleomsætning i stå. Langtidseffekterne (>15-20 år) ukendte. God effekt på knoglefrakturer. Få bivirkninger (kvalme opkastninger, diarre, let feber, let hypocalcæmi). 4. [PTH 1-34: Ved indgift subkutant 1 gang dagligt kan PTH og analoger heraf (PTH1-34) virke anabolisk på knoglerne ved akut stimulering af osteblastudvikling og aktivitet]. 6.sem. ord. 04/05 15
16 5. Hormonbehandling: Østrogen virker fremmende på knogledannelse ved stimulation af bl.a. osteoblastaktvitet. Behandling af postmenopausale kvinder i forbindelse med menopausen med østrogener substituerer for det faldende østrogenniveau efter menopausen.) Medicinsk videnskabsteori Patienten findes velegnet til at indgå i et klinisk kontrolleret behandlingsforsøg. 1. Angiv begrundelserne for kravet om informeret samtykker i lægevidenskabelig forskning. I forbindelse med klinisk forskning er målet ikke specifikt at gavne den enkelte patient som deltager i et forsøg, men at gavne fremtidige patienter. Det at indrullere en patient i et forsøg uden dennes viden er ikke en paternalistisk handling, men en ren og skær krænkelse af personens ret til selvbestemmelse. Kravet om informeret samtykke til deltagelse i kliniske forskning er begrundet i et ønske om at beskytte personer mod tvang og bedrag og i et ønske om at sikre, at de selv tager stilling til, hvorvidt de ønsker at handle altruistisk.) 2. Angiv 4 væsentlige årsager til fejlslutninger, hvis klinikere henholder sig til de erfaringer, de gør i deres daglige arbejde Manglende kendskab til sygdommens spontanforløb, måleusikkerhed og regression mod gennemsnittet, tilfældighederne spil, bias og placeboeffekten). 3. Angiv hvilken type sygdomsenhed, patientens sygdom kan henføres til. Der er tale om et klinisk syndrom) 4. Et kontrolleret behandlingsforsøg giver et statistisk signifikant resultat (p= 0,04). Hvordan fortolkes denne oplysning? P-værdien angiver sandsynligheden for at få det fundne resultat givet at 0-hypotesen er sand. For at tage stilling til om 0-hypotesen skal accepteres eller forkastes, må man ud over p-værdien inddrage sin forhåndstiltro til 0-hypotesen). 6.sem. ord. 04/05 16
17 Miljømedicin Det viser sig, at kvinden udover svær osteoporose også har betydelig nedsat nyrefunktion. Hun spørger, om det kan have noget at gøre med, at jorden, hvor hendes kolonihave ligger, har vist sig at være meget forurenet fra en metalvirksomhed, der tidligere var i området. Hun har i mange år spist alle de grøntsager, hun kunne nå at dyrke i kolonihaven. 1. Angiv hvilken forurening, der kan have forårsaget patientens tilstand, og forklar mekanismen og eksponeringsvejen. Kadmium, som ophobes i grøntsager (op til 25 gange fra omgivende jord) og er nefrotoksisk. Osteoporosen kan være sekundær til nefropatien via manglende D-vitamin aktivering, men det menes også at kadmium direkte kan forstyrre kalciumhomeostasen.) 2. Angiv principper for risikovurdering. a: risikoidentifikation, b: dosis-responsestimering, c: eksponeringsvurdering) 3. Diskuter, hvordan man ved hjælp af disse principper for risikovurdering kan fastsætte grænseværdier for farlige stoffer i jord til kolonihavebrug. a: hvilke stoffer og hvilke kritiske effekter er der tale om, b: hvordan er sammenhængen mellem dosis og respons, hvad er no-effekt level for de kritiske effekter og hvilken usikkerhed er der på evt. ekstrapolation fra dyreforsøg til eksponering for mennesker det fører til fastsættelse af PTWI provisional tolerable weekly intake eller ADI - acceptable daily intake; c: hvor meget og hvordan udsættes man for stoffet via jorden. Grænseværdien fås ved at dividere jordmængden man udsættes for med PTWI eller ADI.) 6.sem. ord. 04/05 17
18 TEMA D. Bevægeapparatet En 85-årig kvinde indbringes på skadestuen efter fald i hjemmet. Hun kan ikke støtte på højre ben og klager over smerter i hoften. Røntgenbillede viser fraktur i højre hofteregion. 1. Angiv de 2 hyppigste hoftenære frakturer hos voksne. Collum femoris frakturer (intrakapsulære, mediale frakturer) og Pertrochantære frakturer (extrakapsulære, laterale frakturer)) 2. Hvorledes inddeles hver af disse to frakturtyper? Collum femoris frakturer: Uforskudte brud (Garden type 1 2) og forskudte brud (Garden type 3 4). Pertrochantære frakturer: Evans type 1 5 ( Type 1 uforskudt, Type 2-5 forskudt med afsprængning af t. minor og/eller t. major)) 3. Hvorledes vil man oftest behandle hver af disse frakturtyper hos en i øvrigt rask patient over 80 år? Collum femoris frakturer, uforskudt: Osteosyntese med kanylerede skruer eller DHS. Collum femoris frakturer, forskudt: Hemialloplastik eller total hofte alloplastik. Pertrochantære frakturer: Reposition og osteosyntese med DHS (dynamisk hofte skrue)) 4. Angiv de vigtigste senkomplikationer til de to frakturtyper. Collum femoris frakturer: Caput nekrose og manglende heling Pertrochantære frakturer: Sekundær frakturskred) 5. Hvilken lidelse vil du mistænke, såfremt en patient med lav knoglemasse har normalt ioniseret calcium og moderat forhøjelse af basisk fosfatase og PTH (parathyreoideahormon)? Osteomalaci D-vitaminmangel sygdom) 6.sem. ord. 04/05 18
19 HERTIL FØJES SPØRGSMÅL FRA DE PARAKLINISKE FAG OG FRA PANUMFAGENE Patologisk anatomi 1. Histologisk undersøgelse af knoglevæv efter fraktur viser adenokarcinom. Hvilken patoanatomisk metode anvendes til nærmere karakteristik af tumor med henblik på udgangspunkt? Immunhistokemi) 2. Beskriv i korthed princippet bag denne undersøgelse. Antistof konjugeret med visualiseringssystem rettet mod vævs/organkarakteristisk antigen) Radiologi 1. Patienten har klinisk en hoftenær fraktur, men du kan ikke se nogen på røntgenbilledet. Angiv 2 muligheder for at komme diagnostisk videre, og angiv hvornår de skal gennemføres. Udredning I: Gentage røntgenundersøgelsen efter 3 dage, Udredning II: Knogleskintigrafi efter 3 dage, III: MR-skanning umiddelbart) Farmakologi 1. Angiv fordele og ulemper ved smertebehandling med hhv. acetylsalicylsyre (ASA) og paracetamol. Paracetamol virker analgetisk (men ikke hos alle). Er næppe særligt effektivt, hvis der er inflammation. Har ingen bivirkninger i analgetisk dosering. ASA virker både analgetisk og antiinflammatorisk, men har i modsætning til paracetamol en række bivirkninger: Ulcus/gastrit, hæmmet thrombocyt-funktion (blødningsproblematik, tromboseprofylakse), nefro-toksicitet samt intolerance.) sem. ord. 04/05 19
Diagnostik af pneumonier - og hvad med den kolde
 Diagnostik af pneumonier og hvad med den kolde Klinisk Mikrobiologisk Afdeling Odense Universitetshospital Pneumoni Diagnosen: HOSPITAL: Stilles på klinik og bekræftes af røntgenundersøgelse af thorax
Diagnostik af pneumonier og hvad med den kolde Klinisk Mikrobiologisk Afdeling Odense Universitetshospital Pneumoni Diagnosen: HOSPITAL: Stilles på klinik og bekræftes af røntgenundersøgelse af thorax
Knogleskørhed (osteoporose)
 Information til patienten Knogleskørhed (osteoporose) Regionshospitalet Viborg Klinik for Diabetes og Hormonsygdomme Hvad er knogleskørhed Knogleskørhed - også kaldet osteoporose - rammer hver 3. kvinde
Information til patienten Knogleskørhed (osteoporose) Regionshospitalet Viborg Klinik for Diabetes og Hormonsygdomme Hvad er knogleskørhed Knogleskørhed - også kaldet osteoporose - rammer hver 3. kvinde
KOL FOR PRAKSISPERSONALE
 KOL FOR PRAKSISPERSONALE Sygeplejerske Lisa Piontek Lisa Piontek Ansat i almen lægepraksis i Søborg i 12 år Ingen interessekonflikter Program Definition Udredning (anamnese, spirometri) Klassifikation
KOL FOR PRAKSISPERSONALE Sygeplejerske Lisa Piontek Lisa Piontek Ansat i almen lægepraksis i Søborg i 12 år Ingen interessekonflikter Program Definition Udredning (anamnese, spirometri) Klassifikation
Lyme Artrit (Borrelia Gigt)
 www.printo.it/pediatric-rheumatology/dk/intro Lyme Artrit (Borrelia Gigt) Version af 2016 1. HVAD ER LYME ARTRIT (BORRELIA GIGT) 1.1 Hvad er det? Borrelia gigt (Lyme borreliosis) er en af de sygdomme,
www.printo.it/pediatric-rheumatology/dk/intro Lyme Artrit (Borrelia Gigt) Version af 2016 1. HVAD ER LYME ARTRIT (BORRELIA GIGT) 1.1 Hvad er det? Borrelia gigt (Lyme borreliosis) er en af de sygdomme,
varskrivelse 131 praktiserende læg Gode råd hvis nogen i familien har en luftvejsinfektion Patientinformation
 Patientinformation Gode råd hvis nogen i familien har en luftvejsinfektion varskrivelse 131 praktiserende læg Et europæisk projekt for praktiserende læger LUFTVEJSINFEKTIONER I ALMEN PRAKS Virus eller
Patientinformation Gode råd hvis nogen i familien har en luftvejsinfektion varskrivelse 131 praktiserende læg Et europæisk projekt for praktiserende læger LUFTVEJSINFEKTIONER I ALMEN PRAKS Virus eller
www.printo.it/pediatric-rheumatology/dk/intro
 www.printo.it/pediatric-rheumatology/dk/intro Blau syndrom Version af 2016 1. HVAD ER BLAU SYNDROM/JUVENIL SARKOIDOSE 1.1 Hvad er det? Blau syndrom er en genetisk sygdom. Som patient lider man af en kombination
www.printo.it/pediatric-rheumatology/dk/intro Blau syndrom Version af 2016 1. HVAD ER BLAU SYNDROM/JUVENIL SARKOIDOSE 1.1 Hvad er det? Blau syndrom er en genetisk sygdom. Som patient lider man af en kombination
Forstå dine laboratorieundersøgelser. myelomatose
 Forstå dine laboratorieundersøgelser ved myelomatose Denne vejledning giver indblik i de målinger og undersøgelser, der udføres hos patienter med myelomatose. Resultaterne af disse målinger og undersøgelser
Forstå dine laboratorieundersøgelser ved myelomatose Denne vejledning giver indblik i de målinger og undersøgelser, der udføres hos patienter med myelomatose. Resultaterne af disse målinger og undersøgelser
Lungefunktionsundersøgelse. LKO-kursus 6/ Helle Dall Madsen og Bettina Dalsgaard lungemedicinsk afd. J. OUH.
 Lungefunktionsundersøgelse LKO-kursus 6/2 2018 Helle Dall Madsen og Bettina Dalsgaard lungemedicinsk afd. J. OUH. Hvorfor LFU Vigtig ved udredning af pt. med dyspnø. Kan bruges som led i differential diagnostisk
Lungefunktionsundersøgelse LKO-kursus 6/2 2018 Helle Dall Madsen og Bettina Dalsgaard lungemedicinsk afd. J. OUH. Hvorfor LFU Vigtig ved udredning af pt. med dyspnø. Kan bruges som led i differential diagnostisk
KOL. Kronisk Obstruktiv Lungesygdom. KOL (kronisk obstruktiv lungesygdom) er en betegnelse, som omfatter kronisk bronkitis og emfysem.
 KOL skyldes sædvanligvis tobaksrygning. Det er derfor, sygdommen også kaldes for»rygerlunger«. Symptomerne er hoste og kortåndethed. Den vigtigste behandling er ophør med rygning. Forskellig inhaleret
KOL skyldes sædvanligvis tobaksrygning. Det er derfor, sygdommen også kaldes for»rygerlunger«. Symptomerne er hoste og kortåndethed. Den vigtigste behandling er ophør med rygning. Forskellig inhaleret
Børnelægeklinikken v/elise Snitker Jensen Boulevarden 9 9000 Aalborg Tlf. 98130100. Information til forældre om astma
 Information til forældre om astma Hvad er astma? Astma er en tilstand med en kombination af irriterede og hævede slimhinder i luftrørene og kramper i musklerne omkring luftrørene. De hævede slimhinder
Information til forældre om astma Hvad er astma? Astma er en tilstand med en kombination af irriterede og hævede slimhinder i luftrørene og kramper i musklerne omkring luftrørene. De hævede slimhinder
Patientinformation DBCG 04-b
 information DBCG 04-b Behandling af brystkræft efter operation De har nu overstået operationen for brystkræft. Selvom hele svulsten er fjernet ved operationen, er der alligevel i nogle tilfælde en risiko
information DBCG 04-b Behandling af brystkræft efter operation De har nu overstået operationen for brystkræft. Selvom hele svulsten er fjernet ved operationen, er der alligevel i nogle tilfælde en risiko
Behandling af Crohn s sygdom med lægemidlet Methotrexat
 Hillerød Hospital Kirurgisk Afdeling Behandling af Crohn s sygdom med lægemidlet Methotrexat Patientinformation April 2011 Forfatter: Gastro-medicinsk ambulatorium Hillerød Hospital Kirurgisk Afdeling
Hillerød Hospital Kirurgisk Afdeling Behandling af Crohn s sygdom med lægemidlet Methotrexat Patientinformation April 2011 Forfatter: Gastro-medicinsk ambulatorium Hillerød Hospital Kirurgisk Afdeling
Lungesygdomme. Astma og Kronisk Obstruktiv Lungelidelse
 Lungesygdomme Astma og Kronisk Obstruktiv Lungelidelse http://www.irf.dk/dk/publikationer/maanedsblad/behandling_af_astma_og_kronisk_obstruktiv_.htm http://www.irf.dk/dk/publikationer/kol_rev.htm http://www.irf.dk/dk/publikationer/maanedsblad/akut_exacerbation_af_kol.htm
Lungesygdomme Astma og Kronisk Obstruktiv Lungelidelse http://www.irf.dk/dk/publikationer/maanedsblad/behandling_af_astma_og_kronisk_obstruktiv_.htm http://www.irf.dk/dk/publikationer/kol_rev.htm http://www.irf.dk/dk/publikationer/maanedsblad/akut_exacerbation_af_kol.htm
Anette Spohr Dyrlæge, ph.d
 Akut diarrebehandling og rådgvining Anette Spohr Dyrlæge, ph.d Definition Akut opstået symptomer fra GI kanalen Symptomer Diarre Vomitus Feber Anorexi Shock Dyspnea Abdominale smerter Klassifikation Akutte
Akut diarrebehandling og rådgvining Anette Spohr Dyrlæge, ph.d Definition Akut opstået symptomer fra GI kanalen Symptomer Diarre Vomitus Feber Anorexi Shock Dyspnea Abdominale smerter Klassifikation Akutte
Patientvejledning. Lungebetændelse/pneumoni
 Patientvejledning Lungebetændelse/pneumoni Du er indlagt med en lungebetændelse/pneumoni Lungebetændelse er en utrolig hyppig sygdom, der er skyld i op mod 20.000 indlæggelser hvert år i Danmark Lungebetændelse
Patientvejledning Lungebetændelse/pneumoni Du er indlagt med en lungebetændelse/pneumoni Lungebetændelse er en utrolig hyppig sygdom, der er skyld i op mod 20.000 indlæggelser hvert år i Danmark Lungebetændelse
Information til forældre om astma
 Information til forældre om astma Børnelægeklinikken v/elise Snitker Jensen Hvad er astma? Astma er en tilstand med en kombination af irriterede og hævede slimhinder i luftrørene og kramper i musklerne
Information til forældre om astma Børnelægeklinikken v/elise Snitker Jensen Hvad er astma? Astma er en tilstand med en kombination af irriterede og hævede slimhinder i luftrørene og kramper i musklerne
SARKOIDOSE. Regionshospitalet Silkeborg. Diagnostisk Center Lungeambulatoriet
 SARKOIDOSE Regionshospitalet Silkeborg Diagnostisk Center Lungeambulatoriet HVAD ER SARKOIDOSE? Sarkoidose hedder også Boecks sygdom, opkaldt efter en norsk lungelæge. Der findes ikke noget dansk navn
SARKOIDOSE Regionshospitalet Silkeborg Diagnostisk Center Lungeambulatoriet HVAD ER SARKOIDOSE? Sarkoidose hedder også Boecks sygdom, opkaldt efter en norsk lungelæge. Der findes ikke noget dansk navn
Luftvejslidelser, hoste og nedsat præstation
 Luftvejslidelser, hoste og nedsat præstation Det er vigtigt at vide som hesteejer, at det som udgangspunkt altid er unormalt for hesten at have hoste eller bilyde i forbindelse med vejrtrækning, enten
Luftvejslidelser, hoste og nedsat præstation Det er vigtigt at vide som hesteejer, at det som udgangspunkt altid er unormalt for hesten at have hoste eller bilyde i forbindelse med vejrtrækning, enten
Somatisk sygdomslære og farmakologi
 Somatisk sygdomslære og farmakologi - Supplerende materiale til i-bogen Kapitel 1 Mikrobiologi og hygiejne Side 15 Power point med illustrationer og tabeller for kapitel 1 Side 19 Side 25 Side 32 Side
Somatisk sygdomslære og farmakologi - Supplerende materiale til i-bogen Kapitel 1 Mikrobiologi og hygiejne Side 15 Power point med illustrationer og tabeller for kapitel 1 Side 19 Side 25 Side 32 Side
Kræft. Symptomer Behandling Forløb. Jon Kroll Bjerregaard ph.d. læge Thea Otto Mattsson stud. ph.d. læge
 Kræft Symptomer Behandling Forløb Jon Kroll Bjerregaard ph.d. læge Thea Otto Mattsson stud. ph.d. læge Hvad vil vi Basis Baggrund - Basisviden Opsummering Hudkræft Praksis Kræft - Forløb Bivirkninger Symptomer
Kræft Symptomer Behandling Forløb Jon Kroll Bjerregaard ph.d. læge Thea Otto Mattsson stud. ph.d. læge Hvad vil vi Basis Baggrund - Basisviden Opsummering Hudkræft Praksis Kræft - Forløb Bivirkninger Symptomer
Patientinformation DBCG 2007- b,t
 information DBCG 2007- b,t Behandling af brystkræft efter operation De har nu overstået operationen for brystkræft. Selvom hele svulsten er fjernet ved operationen, er der alligevel i nogle tilfælde en
information DBCG 2007- b,t Behandling af brystkræft efter operation De har nu overstået operationen for brystkræft. Selvom hele svulsten er fjernet ved operationen, er der alligevel i nogle tilfælde en
www.printo.it/pediatric-rheumatology/dk/intro
 www.printo.it/pediatric-rheumatology/dk/intro Majeed Version af 2016 1. HVAD ER MAJEED 1.1 Hvad er det? Majeed er en sjælden genetisk sygdom. Børn med denne sygdom lider af CRMO (kronisk rekurrent multifokal
www.printo.it/pediatric-rheumatology/dk/intro Majeed Version af 2016 1. HVAD ER MAJEED 1.1 Hvad er det? Majeed er en sjælden genetisk sygdom. Børn med denne sygdom lider af CRMO (kronisk rekurrent multifokal
Guide: Sådan minimerer du risikoen for KOL-følgesygdomme
 Guide: Sådan minimerer du risikoen for KOL-følgesygdomme Tre simple blodprøver kan forudsige, hvem af de 430.000 danske KOL-patienter, der er i størst risiko for at udvikle de følgesygdomme, der oftest
Guide: Sådan minimerer du risikoen for KOL-følgesygdomme Tre simple blodprøver kan forudsige, hvem af de 430.000 danske KOL-patienter, der er i størst risiko for at udvikle de følgesygdomme, der oftest
Gigtfeber og post-streptokok reaktiv artritis
 www.printo.it/pediatric-rheumatology/dk/intro Gigtfeber og post-streptokok reaktiv artritis Version af 2016 2. DIAGNOSE OG BEHANDLING 2.1 Hvordan diagnosticeres sygdommen? Der findes ikke nogen specifik
www.printo.it/pediatric-rheumatology/dk/intro Gigtfeber og post-streptokok reaktiv artritis Version af 2016 2. DIAGNOSE OG BEHANDLING 2.1 Hvordan diagnosticeres sygdommen? Der findes ikke nogen specifik
Lungebetændelse/ Pneumoni
 Lungebetændelse/ Pneumoni Information til patienter Regionshospitalet Silkeborg Diagnostisk Center Sengeafsnit M1/M2/M3 Hvad er lungebetændelse? Du er indlagt med en lungebetændelse/pneumoni, som er en
Lungebetændelse/ Pneumoni Information til patienter Regionshospitalet Silkeborg Diagnostisk Center Sengeafsnit M1/M2/M3 Hvad er lungebetændelse? Du er indlagt med en lungebetændelse/pneumoni, som er en
http://medlem.apoteket.dk/pjecer/html/direkte/2008-direkte-02.htm
 Side 1 af 5 Nr. 2 \ 2008 Behandling af KOL - Kronisk Obstruktiv Lungesygdom Af farmaceut Hanne Fischer KOL (Kronisk Obstruktiv Lungesygdom) er en lungesygdom, som ca. 430.000 danskere lider af. Rygning
Side 1 af 5 Nr. 2 \ 2008 Behandling af KOL - Kronisk Obstruktiv Lungesygdom Af farmaceut Hanne Fischer KOL (Kronisk Obstruktiv Lungesygdom) er en lungesygdom, som ca. 430.000 danskere lider af. Rygning
INDBERETTEDE BIVIRKNINGER I FORBINDELSE MED MEDICINSK BEHANDLING AF OSTEOPOROSE
 INDBERETTEDE BIVIRKNINGER I FORBINDELSE MED MEDICINSK BEHANDLING AF OSTEOPOROSE 2013 Titel Indberettede bivirkninger i forbindelse med medicinsk behandling af osteoporose Sundhedsstyrelsen, 2013. Publikationen
INDBERETTEDE BIVIRKNINGER I FORBINDELSE MED MEDICINSK BEHANDLING AF OSTEOPOROSE 2013 Titel Indberettede bivirkninger i forbindelse med medicinsk behandling af osteoporose Sundhedsstyrelsen, 2013. Publikationen
Mette Friberg Hitz. speciallæge i endokrinologi overlæge, ph.d osteoporose enheden hvidovre hospital
 OSTEOPOROSE WORK-SHOP KØGE 20.05.2014 Nyt om osteoporose... Mette Friberg Hitz speciallæge i endokrinologi overlæge, ph.d osteoporose enheden hvidovre hospital HVAD ER OSTEOPOROSE HVAD SKER DER I KNOGLERNE,
OSTEOPOROSE WORK-SHOP KØGE 20.05.2014 Nyt om osteoporose... Mette Friberg Hitz speciallæge i endokrinologi overlæge, ph.d osteoporose enheden hvidovre hospital HVAD ER OSTEOPOROSE HVAD SKER DER I KNOGLERNE,
Målepunkter vedr. reumatologi for Sundhedsstyrelsens tilsyn med private behandlingssteder
 Målepunkter vedr. reumatologi for Sundhedsstyrelsens tilsyn med private behandlingssteder 30. januar 2014 1. Reumatoid artrit 1.1 Journal: Udredning Gennemgang af et antal journaler viste, at nydiagnosticerede
Målepunkter vedr. reumatologi for Sundhedsstyrelsens tilsyn med private behandlingssteder 30. januar 2014 1. Reumatoid artrit 1.1 Journal: Udredning Gennemgang af et antal journaler viste, at nydiagnosticerede
KOL BORGERE I SLAGELSE KOMMUNE
 KOL BORGERE I SLAGELSE KOMMUNE GENERELT OM KOL 430.000 BORGERE MED KOL I DK 25.000 INDLÆGGELSER ÅRLIGT 4000 DØDSFALD ÅRLIGT VIDEN OM KOL KOL ER EN IRREVERSIBEL LUNGE LIDELSE LIDELSEN ER FORÅRSAGET AF RYGNING,
KOL BORGERE I SLAGELSE KOMMUNE GENERELT OM KOL 430.000 BORGERE MED KOL I DK 25.000 INDLÆGGELSER ÅRLIGT 4000 DØDSFALD ÅRLIGT VIDEN OM KOL KOL ER EN IRREVERSIBEL LUNGE LIDELSE LIDELSEN ER FORÅRSAGET AF RYGNING,
Hvad er KOL. Kronisk sygdom i luftveje og lunger. KOL er en folkesygdom. Mange navne. KOL er ikke det samme som astma
 Hvad er KOL Kronisk sygdom i luftveje og lunger KOL er en folkesygdom Mange navne Kronisk bronkitis og for store lunger Rygerlunger KOL er ikke det samme som astma Praktisk definition Vedvarende nedsat
Hvad er KOL Kronisk sygdom i luftveje og lunger KOL er en folkesygdom Mange navne Kronisk bronkitis og for store lunger Rygerlunger KOL er ikke det samme som astma Praktisk definition Vedvarende nedsat
Til dig, der kan blive alvorligt syg af influenza. råd om vaccination mod influenza. 2009 På den sikre side
 Til dig, der kan blive alvorligt syg af influenza råd om vaccination mod influenza 2009 På den sikre side Information om vaccinerne Vaccination beskytter de fleste Vaccination mod influenza beskytter de
Til dig, der kan blive alvorligt syg af influenza råd om vaccination mod influenza 2009 På den sikre side Information om vaccinerne Vaccination beskytter de fleste Vaccination mod influenza beskytter de
Definition Hyppighed Risikofaktorer Undersøgelser Behandling Overordnede træningsprincipper
 Definition Hyppighed Risikofaktorer Undersøgelser Behandling Overordnede træningsprincipper En tilstand, hvor knoglemasse/styrke er nedsat i en sådan grad, at der kan opstå brud ved lettere belastning
Definition Hyppighed Risikofaktorer Undersøgelser Behandling Overordnede træningsprincipper En tilstand, hvor knoglemasse/styrke er nedsat i en sådan grad, at der kan opstå brud ved lettere belastning
Behandling af brystkræft
 information DBCG 2010-neo-c (Letrozol) Behandling af brystkræft Behandling af brystkræft omfatter i de fleste tilfælde en kombination af lokalbehandling (operation og eventuel strålebehandling) samt medicinsk
information DBCG 2010-neo-c (Letrozol) Behandling af brystkræft Behandling af brystkræft omfatter i de fleste tilfælde en kombination af lokalbehandling (operation og eventuel strålebehandling) samt medicinsk
SPONDYLITIS. Ebbe Stender Hansen. Rygkirurgisk symposium 21/3 2011
 SPONDYLITIS Ebbe Stender Hansen Rygkirurgisk symposium 21/3 2011 Spondylitis infektion i Vertebrae Disci Paravertebralt Epiduralt M. psoas Patogenese 1 - bakteriæmi Sår, abcesser UVI Øvre luftveje Stiknarkomani
SPONDYLITIS Ebbe Stender Hansen Rygkirurgisk symposium 21/3 2011 Spondylitis infektion i Vertebrae Disci Paravertebralt Epiduralt M. psoas Patogenese 1 - bakteriæmi Sår, abcesser UVI Øvre luftveje Stiknarkomani
Kronisk obstruktiv lungesygdom. Pia Holland Gjørup Afdelingslæge Hospitalsenheden Vest
 Kronisk obstruktiv lungesygdom Pia Holland Gjørup Afdelingslæge Hospitalsenheden Vest Interessekonflikter KOL Fibrose Bronkiolit Slim Inflammation Emfysem Bronkiektasier Destruktion af parenchym Tab af
Kronisk obstruktiv lungesygdom Pia Holland Gjørup Afdelingslæge Hospitalsenheden Vest Interessekonflikter KOL Fibrose Bronkiolit Slim Inflammation Emfysem Bronkiektasier Destruktion af parenchym Tab af
Inhalationssteroid til KOL-patienter
 BUDSKABER Inhalationssteroid til KOL-patienter Analyser af forbrug af inhalationssteroid (ICS) til KOL-patienter i almen praksis tyder på, at flere patienter end anbefalet behandles med inhalationssteroider.
BUDSKABER Inhalationssteroid til KOL-patienter Analyser af forbrug af inhalationssteroid (ICS) til KOL-patienter i almen praksis tyder på, at flere patienter end anbefalet behandles med inhalationssteroider.
Astmamedicin. lungesygdommen KOL.
 Astmamedicin Denne brochure handler om medicin til behandling af astma. En medicin, der også bliver brugt mod astmatisk bronkitis hos børn og til behandling af voksne med lungesygdommen KOL. Hvad er astma?
Astmamedicin Denne brochure handler om medicin til behandling af astma. En medicin, der også bliver brugt mod astmatisk bronkitis hos børn og til behandling af voksne med lungesygdommen KOL. Hvad er astma?
Modul 09a F902a-2. Dysregulering og analyser af Calcium-Fosfat Stofskiftet
 Modul 09a F902a-2 Dysregulering og analyser af Calcium-Fosfat Stofskiftet Søren Frank Jørgensen Lektor Navn Navnesen Titel Side 1 Afdelning 10 august 2009 Ændringer til næste gang. FO i dysreg er nu lidt
Modul 09a F902a-2 Dysregulering og analyser af Calcium-Fosfat Stofskiftet Søren Frank Jørgensen Lektor Navn Navnesen Titel Side 1 Afdelning 10 august 2009 Ændringer til næste gang. FO i dysreg er nu lidt
ASTMA ASTMA. ved man ikke med sikkerhed. Nogle astmatikere har også allergi.
 Astma ASTMA Astma er en sygdom i luftvejene, der kan starte når som helst i livet oftest som barn, men også som voksen eller ældre. Astma kan være arveligt, men hvad der udløser sygdommen hos nogle og
Astma ASTMA Astma er en sygdom i luftvejene, der kan starte når som helst i livet oftest som barn, men også som voksen eller ældre. Astma kan være arveligt, men hvad der udløser sygdommen hos nogle og
IL-1 receptor antagonist mangel (DIRA)
 www.printo.it/pediatric-rheumatology/dk/intro IL-1 receptor antagonist mangel (DIRA) Version af 2016 1. HVAD ER DIRA 1.1 Hvad er det? IL-1 receptor antagonist mangel (Deficiency of IL-1Receptor Antagonist,
www.printo.it/pediatric-rheumatology/dk/intro IL-1 receptor antagonist mangel (DIRA) Version af 2016 1. HVAD ER DIRA 1.1 Hvad er det? IL-1 receptor antagonist mangel (Deficiency of IL-1Receptor Antagonist,
Rejsevejledning og udenlandsvaccination
 Skift farvedesign Gå til Design i Topmenuen Vælg dit farvedesign fra de seks SOPU-designs Vil du have flere farver, højreklik på farvedesignet og vælg Applicér på valgte slides Rejsevejledning og udenlandsvaccination
Skift farvedesign Gå til Design i Topmenuen Vælg dit farvedesign fra de seks SOPU-designs Vil du have flere farver, højreklik på farvedesignet og vælg Applicér på valgte slides Rejsevejledning og udenlandsvaccination
Henoch-Schönlein s Purpura
 www.printo.it/pediatric-rheumatology/dk/intro Henoch-Schönlein s Purpura Version af 2016 1. HVAD ER HENOCH- SCHÖNLEIN S PURPURA? 1.1. Hvad er det? Henoch-Schönleins purpura (HSP) er en tilstand med inflammation
www.printo.it/pediatric-rheumatology/dk/intro Henoch-Schönlein s Purpura Version af 2016 1. HVAD ER HENOCH- SCHÖNLEIN S PURPURA? 1.1. Hvad er det? Henoch-Schönleins purpura (HSP) er en tilstand med inflammation
Nordjysk Praksisdag 2014
 Nordjysk Praksisdag 2014 - Skæve laboratorieværdier Case En 55 årig kvinde som er træt, kommer i klinikken til en screening Lidt kataralsk, lidt hoste, føler sig lidt varm men har ikke haft feber Får ingen
Nordjysk Praksisdag 2014 - Skæve laboratorieværdier Case En 55 årig kvinde som er træt, kommer i klinikken til en screening Lidt kataralsk, lidt hoste, føler sig lidt varm men har ikke haft feber Får ingen
Hvis man gennem en længere periode har behov for symptomlindrende
 Allergivaccination Allergivaccination Denne brochure henvender sig til dig, der overvejer allergivaccination eller allerede har taget beslutningen om at begynde behandlingen. Formålet er at informere om
Allergivaccination Allergivaccination Denne brochure henvender sig til dig, der overvejer allergivaccination eller allerede har taget beslutningen om at begynde behandlingen. Formålet er at informere om
Astma Astmatisk bronkitis hos børn Patientvejledning, af Thomas Greibe.
 Astma Astmatisk bronkitis hos børn Patientvejledning, af Thomas Greibe. Vejledning om Astma/Astmatisk bronkitis hos småbørn Astmatisk bronkitis hos småbørn er en meget almindelig sygdom. Ca. 20 % af alle
Astma Astmatisk bronkitis hos børn Patientvejledning, af Thomas Greibe. Vejledning om Astma/Astmatisk bronkitis hos småbørn Astmatisk bronkitis hos småbørn er en meget almindelig sygdom. Ca. 20 % af alle
Kender du din lungefunktion?
 Kender du din lungefunktion? En pjece fra Danmarks Lungeforening www.lunge.dk Kend dine lunger Sundere lunger - livet igennem Danmarks Lungeforening arbejder for, at endnu flere danskere lever med sundere
Kender du din lungefunktion? En pjece fra Danmarks Lungeforening www.lunge.dk Kend dine lunger Sundere lunger - livet igennem Danmarks Lungeforening arbejder for, at endnu flere danskere lever med sundere
Alternativ ved penicillinallergi eller anden kontraindikation. Infektionstype. Anbefalet initial behandling
 Infektionstype Anbefalet initial behandling Alternativ ved penicillinallergi anden kontraindikation Sepsis af ukendt fokus Sepsis 1,2 benzylpenicillin 1,2 g x 4 iv cefotaxim 1 g x 3 iv evt. gentamicin
Infektionstype Anbefalet initial behandling Alternativ ved penicillinallergi anden kontraindikation Sepsis af ukendt fokus Sepsis 1,2 benzylpenicillin 1,2 g x 4 iv cefotaxim 1 g x 3 iv evt. gentamicin
Patientinformation DBCG 2009- b,t. Behandling af brystkræft efter operation
 Behandling af brystkræft efter operation information DBCG 2009- b,t Du har nu overstået operationen for brystkræft. Selvom hele svulsten er fjernet ved operationen, er der alligevel i nogle tilfælde en
Behandling af brystkræft efter operation information DBCG 2009- b,t Du har nu overstået operationen for brystkræft. Selvom hele svulsten er fjernet ved operationen, er der alligevel i nogle tilfælde en
Antibiotika? kun når det er nødvendigt!
 Antibiotika? kun når det er nødvendigt! Brug af antibiotika kan føre til, at bakterierne bliver modstandsdygtige over for antibiotika. Det kan dermed blive sværere at få bugt med en ny infektion. Antibiotika
Antibiotika? kun når det er nødvendigt! Brug af antibiotika kan føre til, at bakterierne bliver modstandsdygtige over for antibiotika. Det kan dermed blive sværere at få bugt med en ny infektion. Antibiotika
Birk (Betula verrucosa) Græs (Phleum Pratense)
 Allergivaccination Allergivaccination 3 Denne brochure henvender sig til dig, der overvejer allergi vaccination eller allerede har taget beslutningen om at begynde behandlingen. Formålet er at informere
Allergivaccination Allergivaccination 3 Denne brochure henvender sig til dig, der overvejer allergi vaccination eller allerede har taget beslutningen om at begynde behandlingen. Formålet er at informere
Udredning ved mistanke om kræ1 Lægedage 2015
 Udredning ved mistanke om kræ1 Lægedage 2015 Claus Larsen Felto. Diagnos2sk Enhed, Medicinsk Afd O Herlev Hospital Organisering af kræ.udredning Kræ.plan I (2000) Kræ.plan II (2005) Kræ.plan III (2011):
Udredning ved mistanke om kræ1 Lægedage 2015 Claus Larsen Felto. Diagnos2sk Enhed, Medicinsk Afd O Herlev Hospital Organisering af kræ.udredning Kræ.plan I (2000) Kræ.plan II (2005) Kræ.plan III (2011):
Information til patienten. Infektioner. - hos nyfødte og for tidligt fødte børn. Børneafdeling C1 Hospitalsenheden Vest
 Information til patienten Infektioner - hos nyfødte og for tidligt fødte børn Børneafdeling C1 Hospitalsenheden Vest Infektioner hos nyfødte og for tidligt fødte Nyfødte børn kan få mange forskellige
Information til patienten Infektioner - hos nyfødte og for tidligt fødte børn Børneafdeling C1 Hospitalsenheden Vest Infektioner hos nyfødte og for tidligt fødte Nyfødte børn kan få mange forskellige
Lændesmerter - lave rygsmerter
 Lændesmerter - lave rygsmerter Hvad er lave rygsmerter? Lave rygsmerter er smerter i nedre del af ryggen (lænderyggen), hvor der ikke findes nogen sikker forklaring på smerterne i form af sygdomme eller
Lændesmerter - lave rygsmerter Hvad er lave rygsmerter? Lave rygsmerter er smerter i nedre del af ryggen (lænderyggen), hvor der ikke findes nogen sikker forklaring på smerterne i form af sygdomme eller
Familiær middelhavsfeber
 www.printo.it/pediatric-rheumatology/dk/intro Familiær middelhavsfeber Version af 2016 2. DIAGNOSE OG BEHANDLING 2.1 Hvordan diagnosticeres det? Overordnet set anvendes følgende tilgang: Klinisk mistanke:
www.printo.it/pediatric-rheumatology/dk/intro Familiær middelhavsfeber Version af 2016 2. DIAGNOSE OG BEHANDLING 2.1 Hvordan diagnosticeres det? Overordnet set anvendes følgende tilgang: Klinisk mistanke:
Knogleskørhed og prostatakræft
 Mads Hvid Poulsen, Læge, Ph.d. Knogleskørhed og prostatakræft Urinvejskirurgisk forskningsenhed, Urologisk Afdeling, Odense Universitets Hospital Folderen er udarbejdet på baggrund af eksisterende litteratur
Mads Hvid Poulsen, Læge, Ph.d. Knogleskørhed og prostatakræft Urinvejskirurgisk forskningsenhed, Urologisk Afdeling, Odense Universitets Hospital Folderen er udarbejdet på baggrund af eksisterende litteratur
Svarark, eksamen modul 2.3 Juni 2011. Spørgsmål Svar Spørgsmål Svar 1 c 7 a 2 a 8 a 3 b 9 a 4 d 10 e 5.1 a 11 d 5.2 c 12 d 5.
 Svarark, eksamen modul 2.3 Juni 2011 Spørgsmål Svar Spørgsmål Svar 1 c 7 a 2 a 8 a 3 b 9 a 4 d 10 e 5.1 a 11 d 5.2 c 12 d 5.3 e 13 b 6 d 14 d Opgave 15 En 50-årig kvinde har haft gestationel DM under to
Svarark, eksamen modul 2.3 Juni 2011 Spørgsmål Svar Spørgsmål Svar 1 c 7 a 2 a 8 a 3 b 9 a 4 d 10 e 5.1 a 11 d 5.2 c 12 d 5.3 e 13 b 6 d 14 d Opgave 15 En 50-årig kvinde har haft gestationel DM under to
Mistanke om alvorlig sygdom ( okkult cancer )
 Mistanke om alvorlig sygdom ( okkult cancer ) Ulrich Fredberg Ledende overlæge Medicinsk Afdeling Regionhospitalet Silkeborg www.regionmidtjylland.dk Regionshospitalet Silkeborg Center of Excellence Akutplanen
Mistanke om alvorlig sygdom ( okkult cancer ) Ulrich Fredberg Ledende overlæge Medicinsk Afdeling Regionhospitalet Silkeborg www.regionmidtjylland.dk Regionshospitalet Silkeborg Center of Excellence Akutplanen
Multipel Endokrin Neoplasi 1 (MEN1) Patientinformation
 Multipel Endokrin Neoplasi 1 (MEN1) Patientinformation MEN1 er en arvelig sygdom, hvor der påvises en eller flere knuder (tumorer) i hormonproducerende kirtler. MEN1 er en sjælden lidelse, som rammer mænd
Multipel Endokrin Neoplasi 1 (MEN1) Patientinformation MEN1 er en arvelig sygdom, hvor der påvises en eller flere knuder (tumorer) i hormonproducerende kirtler. MEN1 er en sjælden lidelse, som rammer mænd
Imadrax Novum, 500 mg, 750 mg og 1000 mg, dispergible tabletter amoxicillin
 INDLÆGSSEDDEL: INFORMATION TIL BRUGEREN Imadrax Novum, 500 mg, 750 mg og 1000 mg, dispergible tabletter amoxicillin Læs denne indlægsseddel grundigt, inden du begynder at tage medicinen. - Gem indlægssedlen.
INDLÆGSSEDDEL: INFORMATION TIL BRUGEREN Imadrax Novum, 500 mg, 750 mg og 1000 mg, dispergible tabletter amoxicillin Læs denne indlægsseddel grundigt, inden du begynder at tage medicinen. - Gem indlægssedlen.
CEREBROSPINALVÆSKER: KLINIK OG MORFOLOGI
 Årsmøde Dansk Cytologiforening 2015 CEREBROSPINALVÆSKER: KLINIK OG MORFOLOGI Ved Helle Broholm Overlæge Patologiafd. Rigshospitalet CSV -CSF cerebro spinal væske (rygmarvsvæske) Hvad er cerebrospinalvæske?
Årsmøde Dansk Cytologiforening 2015 CEREBROSPINALVÆSKER: KLINIK OG MORFOLOGI Ved Helle Broholm Overlæge Patologiafd. Rigshospitalet CSV -CSF cerebro spinal væske (rygmarvsvæske) Hvad er cerebrospinalvæske?
Børnecancerfonden informerer HLH. Hæmofagocytisk lymfohistiocytose _HLH_Informationsbrochure.indd 1 16/05/
 HLH Hæmofagocytisk lymfohistiocytose 31429_HLH_Informationsbrochure.indd 1 16/05/2017 14.46 HLH Hæmofagocytisk lymfohistiocytose 31429_HLH_Informationsbrochure.indd 2 16/05/2017 14.46 3 Fra de danske børnekræftafdelinger
HLH Hæmofagocytisk lymfohistiocytose 31429_HLH_Informationsbrochure.indd 1 16/05/2017 14.46 HLH Hæmofagocytisk lymfohistiocytose 31429_HLH_Informationsbrochure.indd 2 16/05/2017 14.46 3 Fra de danske børnekræftafdelinger
Eksamensopgavesæt KLADDE
 Eksamensopgavesæt KLADDE Skriftlig eksamen i kandidatuddannelse molekylær medicin i faget patologisk anatomi, fredag den 09.10.2015. Til hver eksaminand udleveres ét eksamensopgavesæt (kladde, som kan
Eksamensopgavesæt KLADDE Skriftlig eksamen i kandidatuddannelse molekylær medicin i faget patologisk anatomi, fredag den 09.10.2015. Til hver eksaminand udleveres ét eksamensopgavesæt (kladde, som kan
wilms tumor Børnecancerfonden informerer
 wilms tumor i wilms tumor 3 Sygdomstegn De fleste børn med Wilms tumor viser fra starten kun udvendige sygdomstegn i form af stor mave med synlig og/eller følelig svulst i højre eller venstre side. Svulsten
wilms tumor i wilms tumor 3 Sygdomstegn De fleste børn med Wilms tumor viser fra starten kun udvendige sygdomstegn i form af stor mave med synlig og/eller følelig svulst i højre eller venstre side. Svulsten
Hvad er Myelodysplastisk syndrom (MDS)?
 Hvad er Myelodysplastisk syndrom (MDS)? En information til patienter og pårørende Denne folder støttes af: Patientforeningen for Lymfekræft, Leukæmi og MDS Velkommen Dette hæfte er udviklet for at give
Hvad er Myelodysplastisk syndrom (MDS)? En information til patienter og pårørende Denne folder støttes af: Patientforeningen for Lymfekræft, Leukæmi og MDS Velkommen Dette hæfte er udviklet for at give
Analyser/metoder til undersøgelse af immundefekter
 Analyser/metoder til undersøgelse af immundefekter Læge J. Magnus Bernth Jensen Klinisk Immunologisk afdeling Hvilke analyser til hvilke patienter??? Hvilke patienter bør undersøges? Infektioner er almindelige
Analyser/metoder til undersøgelse af immundefekter Læge J. Magnus Bernth Jensen Klinisk Immunologisk afdeling Hvilke analyser til hvilke patienter??? Hvilke patienter bør undersøges? Infektioner er almindelige
Behandling af brystkræft
 Patientinformation DBCG 2015-neo-c (Letrozol) Behandling af brystkræft Behandling af brystkræft omfatter i de fleste tilfælde en kombination af lokalbehandling (operation og eventuel strålebehandling)
Patientinformation DBCG 2015-neo-c (Letrozol) Behandling af brystkræft Behandling af brystkræft omfatter i de fleste tilfælde en kombination af lokalbehandling (operation og eventuel strålebehandling)
vejledning om ordination af antibiotika Til landets læger med flere
 vejledning om ordination af antibiotika 2012 Til landets læger med flere Vejledning om ordination af antibiotika Sundhedsstyrelsen, 2012. Sundhedsstyrelsen Axel Heides Gade 1 2300 København S URL: http://www.sst.dk
vejledning om ordination af antibiotika 2012 Til landets læger med flere Vejledning om ordination af antibiotika Sundhedsstyrelsen, 2012. Sundhedsstyrelsen Axel Heides Gade 1 2300 København S URL: http://www.sst.dk
Behandling af brystkræft efter operation
 information DBCG 2010-d,t Behandling af brystkræft efter operation Du har nu overstået operationen for brystkræft. Selvom hele svulsten er fjernet ved operationen, er der i nogle tilfælde risiko for, at
information DBCG 2010-d,t Behandling af brystkræft efter operation Du har nu overstået operationen for brystkræft. Selvom hele svulsten er fjernet ved operationen, er der i nogle tilfælde risiko for, at
SLE og Nyreinvolvering
 SLE og Nyreinvolvering Marselisborg Centeret 6 marts 2010 Overlæge Per Ivarsen Nyremedicinsk afdeling Århus Universitetshospital, Skejby Systemisk Lupus Erythromatosus SLE hvor hyppigt er det. 1500-2000
SLE og Nyreinvolvering Marselisborg Centeret 6 marts 2010 Overlæge Per Ivarsen Nyremedicinsk afdeling Århus Universitetshospital, Skejby Systemisk Lupus Erythromatosus SLE hvor hyppigt er det. 1500-2000
18. maj 2011 PRODUKTRESUMÉ. for. Canaural, øredråber, suspension 0. D.SP.NR. 3209. 1. VETERINÆRLÆGEMIDLETS NAVN Canaural
 18. maj 2011 PRODUKTRESUMÉ for Canaural, øredråber, suspension 0. D.SP.NR. 3209 1. VETERINÆRLÆGEMIDLETS NAVN Canaural 2. KVALITATIV OG KVANTITATIV SAMMENSÆTNING 1 g suspension indeholder: Aktive stoffer:
18. maj 2011 PRODUKTRESUMÉ for Canaural, øredråber, suspension 0. D.SP.NR. 3209 1. VETERINÆRLÆGEMIDLETS NAVN Canaural 2. KVALITATIV OG KVANTITATIV SAMMENSÆTNING 1 g suspension indeholder: Aktive stoffer:
Patientinformation. Akut bugspytkirtelbetændelse
 Patientinformation Akut bugspytkirtelbetændelse Kvalitet Døgnet Rundt Kirurgisk Afdeling Akut bugspytkirtelbetændelse Bugspytkirtlen producerer enzymer, som medvirker til fordøjelsen af kosten, vi spiser.
Patientinformation Akut bugspytkirtelbetændelse Kvalitet Døgnet Rundt Kirurgisk Afdeling Akut bugspytkirtelbetændelse Bugspytkirtlen producerer enzymer, som medvirker til fordøjelsen af kosten, vi spiser.
Overordnede diagnostiske strategier for lidelser i bevægeapparatet
 Overlæge Michel Bach Hellfritzsch Radiologisk afd., Nørrebrogade Aarhus Universitetshospital Overordnede diagnostiske strategier for lidelser i bevægeapparatet 1 2 Diagnostiske strategier for muskuloskeletal
Overlæge Michel Bach Hellfritzsch Radiologisk afd., Nørrebrogade Aarhus Universitetshospital Overordnede diagnostiske strategier for lidelser i bevægeapparatet 1 2 Diagnostiske strategier for muskuloskeletal
Kender du din lungefunktion?
 Kender du din lungefunktion? En pjece fra Lungeforeningen www.lunge.dk Sundere lunger - livet igennem Lungeforeningen arbejder for, at flere danskere lever med sundere lunger livet igennem. Din støtte
Kender du din lungefunktion? En pjece fra Lungeforeningen www.lunge.dk Sundere lunger - livet igennem Lungeforeningen arbejder for, at flere danskere lever med sundere lunger livet igennem. Din støtte
Fødevareallergi og intolerance side 2-10
 Indholdsfortegnelse Indledning side 2 Fødevareallergi og intolerance side 2-10 Brød, Boller & Kager side 11-31 Let og lækkert til madpakken eller skovturen side 32-38 Lækre kaloriefattige salater til pålæg
Indholdsfortegnelse Indledning side 2 Fødevareallergi og intolerance side 2-10 Brød, Boller & Kager side 11-31 Let og lækkert til madpakken eller skovturen side 32-38 Lækre kaloriefattige salater til pålæg
Kronisk Obstruktiv Lungesygdom - KOL Har det noget med ens arbejde at gøre? Hvad ved vi i dag?
 Kronisk Obstruktiv Lungesygdom - KOL Har det noget med ens arbejde at gøre? Hvad ved vi i dag? Ingrid Louise Titlestad Overlæge, ph.d., Klinisk Lektor Odense Universitetshospital Svejsekonferencen KOL
Kronisk Obstruktiv Lungesygdom - KOL Har det noget med ens arbejde at gøre? Hvad ved vi i dag? Ingrid Louise Titlestad Overlæge, ph.d., Klinisk Lektor Odense Universitetshospital Svejsekonferencen KOL
Komorbiditet og patienter som ikke umiddelbart passer ind i pakkeforløb
 Lars Onsberg Henriksen, Koncerndirektør Komorbiditet og patienter som ikke umiddelbart passer ind i pakkeforløb Set fra en regional synsvinkel overordnet, strategisk planlægningsmæssigt, og behov for ændret
Lars Onsberg Henriksen, Koncerndirektør Komorbiditet og patienter som ikke umiddelbart passer ind i pakkeforløb Set fra en regional synsvinkel overordnet, strategisk planlægningsmæssigt, og behov for ændret
Visitation af det syge barn i praksis Fredag d. 11. Maj 2012. Visitation af Syge børn i praksis v børnelæge Annette Bache
 Visitation af det syge barn i praksis Fredag d. 11. Maj 2012 Rapport: Danske børn sundhed og sygelighed år 2005 (SUSY 2005) 7000 børn interview forældre (maj 2005-febr 2006) Vigtigste konklusioner: Hver
Visitation af det syge barn i praksis Fredag d. 11. Maj 2012 Rapport: Danske børn sundhed og sygelighed år 2005 (SUSY 2005) 7000 børn interview forældre (maj 2005-febr 2006) Vigtigste konklusioner: Hver
Astma Bronkiale Diagnostik og behandling
 Astma Bronkiale Diagnostik og behandling Lone Agertoft, overlæge/lektor H.C. Andersen Børnehospital Odense Universitetshospital 26.01.17 Case Astma Bronkiale Målet for behandling Få eller ingen symptomer
Astma Bronkiale Diagnostik og behandling Lone Agertoft, overlæge/lektor H.C. Andersen Børnehospital Odense Universitetshospital 26.01.17 Case Astma Bronkiale Målet for behandling Få eller ingen symptomer
COPSAC. Copenhagen Studies on Asthma in Childhood. Astma og immundefekt hos børn. Klaus Bønnelykke Læge, PhD
 COPSAC Copenhagen Studies on Asthma in Childhood Astma og immundefekt hos børn Klaus Bønnelykke Læge, PhD Dansk BørneAstma Center, Gentofte Hospital Program Sammenhængen mellem astma og immundefekt Hvordan
COPSAC Copenhagen Studies on Asthma in Childhood Astma og immundefekt hos børn Klaus Bønnelykke Læge, PhD Dansk BørneAstma Center, Gentofte Hospital Program Sammenhængen mellem astma og immundefekt Hvordan
Antibiotikaguide. Anbefalet initial behandling af udvalgte samfundserhvervede infektioner hos immunkompetente
Antibiotikaguide Anbefalet initial behandling af udvalgte samfundserhvervede infektioner hos immunkompetente voksne Infektionstype Sepsis af ukendt fokus Sepsis 1,2 Anbefalet initial behandling gentamicin
Antibiotikaguide Anbefalet initial behandling af udvalgte samfundserhvervede infektioner hos immunkompetente voksne Infektionstype Sepsis af ukendt fokus Sepsis 1,2 Anbefalet initial behandling gentamicin
Myelomatose generelt. Dansk Myelomatose Forening 13.9.14. Maja Hinge. Læge, stud. ph.d., Hæmatologisk afd., Vejle Sygehus
 Dansk Myelomatose Forening 13.9.14 Myelomatose generelt Maja Hinge. Læge, stud. ph.d., Hæmatologisk afd., Vejle Sygehus Torben Plesner Professor, Overlæge, Hæmatologisk afd., Vejle Sygehus Hvad er myelomatose
Dansk Myelomatose Forening 13.9.14 Myelomatose generelt Maja Hinge. Læge, stud. ph.d., Hæmatologisk afd., Vejle Sygehus Torben Plesner Professor, Overlæge, Hæmatologisk afd., Vejle Sygehus Hvad er myelomatose
www.printo.it/pediatric-rheumatology/dk/intro
 www.printo.it/pediatric-rheumatology/dk/intro PAPA syndromet Version af 2016 1. HVAD ER PAPA 1.1 Hvad er det? PAPA er en forkortelse for Pyogen Artritis, Pyoderma gangrenosum og Akne. Det er en genetisk
www.printo.it/pediatric-rheumatology/dk/intro PAPA syndromet Version af 2016 1. HVAD ER PAPA 1.1 Hvad er det? PAPA er en forkortelse for Pyogen Artritis, Pyoderma gangrenosum og Akne. Det er en genetisk
Anafylaksi Diagnosticering & behandling Hans-Jørgen Malling
 Anafylaksi Diagnosticering & behandling DAC Hans-Jørgen Malling Dansk AllergiCenter Region Hovedstaden Definition af anafylaksi Anafylaksi er en akut, potentielt livstruende tilstand, der skal erkendes
Anafylaksi Diagnosticering & behandling DAC Hans-Jørgen Malling Dansk AllergiCenter Region Hovedstaden Definition af anafylaksi Anafylaksi er en akut, potentielt livstruende tilstand, der skal erkendes
Modic forandringer Er det virkelig antibiotika, der skal til?
 Modic forandringer Er det virkelig antibiotika, der skal til? Ole Kudsk Jensen Reumatolog, ph.d. RegionsRygcentret Forskningsenheden for Sygemeldte Diagnostisk Center Regionshospitalet Silkeborg Hvad er
Modic forandringer Er det virkelig antibiotika, der skal til? Ole Kudsk Jensen Reumatolog, ph.d. RegionsRygcentret Forskningsenheden for Sygemeldte Diagnostisk Center Regionshospitalet Silkeborg Hvad er
FAQ om smertestillende håndkøbspræparater til voksne
 FAQ om smertestillende håndkøbspræparater til voksne 1. Hvilke forskellige typer smertestillende håndkøbspræparater findes der? Der findes smertestillende håndkøbsmedicin som tabletter, hvor det smertestillende
FAQ om smertestillende håndkøbspræparater til voksne 1. Hvilke forskellige typer smertestillende håndkøbspræparater findes der? Der findes smertestillende håndkøbsmedicin som tabletter, hvor det smertestillende
Patientinformation DBCG 2007- d,t
 information DBCG 2007- d,t Behandling af brystkræft efter operation De har nu overstået operationen for brystkræft. Selvom hele svulsten er fjernet ved operationen, er der alligevel i nogle tilfælde en
information DBCG 2007- d,t Behandling af brystkræft efter operation De har nu overstået operationen for brystkræft. Selvom hele svulsten er fjernet ved operationen, er der alligevel i nogle tilfælde en
Behandling af brystkræft
 information DBCG 2010-neo-b Behandling af brystkræft Behandling af brystkræft omfatter i de fleste tilfælde en kombination af lokalbehandling (operation og eventuel strålebehandling) samt medicinsk behandling.
information DBCG 2010-neo-b Behandling af brystkræft Behandling af brystkræft omfatter i de fleste tilfælde en kombination af lokalbehandling (operation og eventuel strålebehandling) samt medicinsk behandling.
Diane 35 grundlæggende version af patientkort og tjekliste til den ordinerende læge 2/11/2014
 Dette lægemiddel er underlagt supplerende overvågning. Dermed kan der hurtigt tilvejebringes nye oplysninger om sikkerheden. Du kan hjælpe ved at indberette alle de bivirkninger, du får. Se i indlægssedlen,
Dette lægemiddel er underlagt supplerende overvågning. Dermed kan der hurtigt tilvejebringes nye oplysninger om sikkerheden. Du kan hjælpe ved at indberette alle de bivirkninger, du får. Se i indlægssedlen,
!! Når!det!er!svært!at!s,lle! diagnosen!astma! 3!Hvad!kan!sygeplejerskens!rolle!være?!
 Nårdetersværtats,lle diagnosenastma 3Hvadkansygeplejerskensrollevære? CelestePorsbjerg Overlæge,ph.d.,kliniskforskningslektor LungemedicinskafdelingL,BispebjergHospital 6% 4% 2% 0% Astma enhyppigsygdomidanmark
Nårdetersværtats,lle diagnosenastma 3Hvadkansygeplejerskensrollevære? CelestePorsbjerg Overlæge,ph.d.,kliniskforskningslektor LungemedicinskafdelingL,BispebjergHospital 6% 4% 2% 0% Astma enhyppigsygdomidanmark
Personalet finder kræft Nordjysk Praksisdag 12. september 2014
 Personalet finder kræft Nordjysk Praksisdag 12. september 2014 Berit Skjødeberg Toftegaard Speciallæge i almen medicin PhD-studerende ved forskningsenheden for almen praksis, Aarhus Moderator: Jens Balle
Personalet finder kræft Nordjysk Praksisdag 12. september 2014 Berit Skjødeberg Toftegaard Speciallæge i almen medicin PhD-studerende ved forskningsenheden for almen praksis, Aarhus Moderator: Jens Balle
CAPRELSA DOSERINGS- OG OVERVÅGNINGSGUIDE TIL PATIENTER OG DERES OMSORGSPERSONER (PÆDIATRISK ANVENDELSE)
 Dette lægemiddel er underlagt supplerende overvågning. Dermed kan nye sikkerhedsoplysninger hurtigt tilvejebringes. Læger og sundhedspersonale anmodes om at indberette alle formodede bivirkninger CAPRELSA
Dette lægemiddel er underlagt supplerende overvågning. Dermed kan nye sikkerhedsoplysninger hurtigt tilvejebringes. Læger og sundhedspersonale anmodes om at indberette alle formodede bivirkninger CAPRELSA
Nervesystemets sygdomme meningitis og hovedpine
 Nervesystemets sygdomme meningitis og hovedpine Meningitis En alvorlig infektion i centralnervesystemet En betændelsestilstand i hjernehinderne og i det subaraknoidale rum Fig. 10.16 1 Årsag til meningitis
Nervesystemets sygdomme meningitis og hovedpine Meningitis En alvorlig infektion i centralnervesystemet En betændelsestilstand i hjernehinderne og i det subaraknoidale rum Fig. 10.16 1 Årsag til meningitis
Svampeskader i boliger og symptomer hos børn Speciallægens perspektiv. Kirsten Skamstrup Hansen ovl.phd. Pædiatrisk Klinik Gentofte
 Svampeskader i boliger og symptomer hos børn Speciallægens perspektiv Kirsten Skamstrup Hansen ovl.phd. Pædiatrisk Klinik Gentofte Speciallægens viden Det ved jeg ikke noget om... Det ved jeg ikke ret
Svampeskader i boliger og symptomer hos børn Speciallægens perspektiv Kirsten Skamstrup Hansen ovl.phd. Pædiatrisk Klinik Gentofte Speciallægens viden Det ved jeg ikke noget om... Det ved jeg ikke ret
MÅLRETTET BEHANDLING AF LUNGEKRÆFT PATIENTINFORMATION OM NYESTE BEHANDLINGSMULIGHEDER
 MÅLRETTET BEHANDLING AF LUNGEKRÆFT PATIENTINFORMATION OM NYESTE BEHANDLINGSMULIGHEDER I løbet af det seneste årti har vi fået langt mere viden om, hvordan kræft udvikler sig. På baggrund af denne viden
MÅLRETTET BEHANDLING AF LUNGEKRÆFT PATIENTINFORMATION OM NYESTE BEHANDLINGSMULIGHEDER I løbet af det seneste årti har vi fået langt mere viden om, hvordan kræft udvikler sig. På baggrund af denne viden
Målepunkter vedr. urologi for Sundhedsstyrelsens tilsyn med private behandlingssteder
 Målepunkter vedr. urologi for Sundhedsstyrelsens tilsyn med private behandlingssteder 6. oktober 2014 1. Krav til udstyr 1.1 Det blev undersøgt om behandlingsstedet var i besiddelse af det nødvendige apparatur,
Målepunkter vedr. urologi for Sundhedsstyrelsens tilsyn med private behandlingssteder 6. oktober 2014 1. Krav til udstyr 1.1 Det blev undersøgt om behandlingsstedet var i besiddelse af det nødvendige apparatur,
Allergivaccination i forbindelse med behandling af allergi og astma
 Allergivaccination i forbindelse med behandling af allergi og astma 3. august 2015 Indholdsfortegnelse 1. Indledning...3 2. Lidt om allergi og astma...3 2.1 Udredning af allergi og astma...3 2.2 Behandlingen
Allergivaccination i forbindelse med behandling af allergi og astma 3. august 2015 Indholdsfortegnelse 1. Indledning...3 2. Lidt om allergi og astma...3 2.1 Udredning af allergi og astma...3 2.2 Behandlingen
